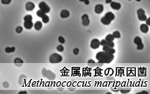
金属腐食の原因菌の写真です。

微生物腐食 ~石油関連施設を対象として~
世界で初めて金属腐食と微生物の直接的な関係を解明することに成功しました
鉄を腐らせる微生物たち
金属腐食とは、通常考えられている耐用年数よりも著しく速く金属が劣化し、破損に至ることです。金属腐食の何割かは微生物によって誘因されていることが古くから知られており、微生物腐食(Moicrobiologically Influenced Corrosion:MIC)と呼ばれてきました。しかし、その原因菌や腐食の機構については全く解明されていないといっても過言ではありません。

本 Web サイトでは、石油設備の腐食に関与する微生物について培養法と分子生物学的手法を駆使することでその一端を明らかにし、対策実施のための基盤的情報の整備を行ったので報告いたします。
本調査では、世界で初めてのいくつかの知見を得ることができました
- 腐食を起こす微生物を単離し純粋培養することに成功
- 金属腐食に微生物が関与していることを直接的に証明
- 微生物による腐食機構を遺伝子レベルで解明
微生物腐食に関与すると思われる微生物の分離・同定
鉄腐食性微生物の腐食機構の解明
微生物腐食対策実施のための基礎的情報の整備
本調査について
本調査は、NITE (独立行政法人 製品評価技術基盤機構)が、新日本製鐵株式会社と共に、NEDO (独立行政法人 新エネルギー・産業技術総合開発機構)からの受託事業として、平成17~20年度に実施しました。
本調査結果が石油資源の輸送・保管にかかる問題解決に取り組む方々に広く活用され、エネルギーや資源の確保と、その利用にあたっての安全と環境の保全に役立ち、地球環境問題への貢献や関連諸国に対する国際的な貢献として意義のあるものとなることを期待しています。

メニュー一覧
お問い合わせ
- 独立行政法人製品評価技術基盤機構 バイオテクノロジーセンター バイオ技術評価・開発課(かずさ)
-
TEL:0438-20-5764
住所:〒292-0818 千葉県木更津市かずさ鎌足2-5-8 地図
お問い合わせフォームへ








